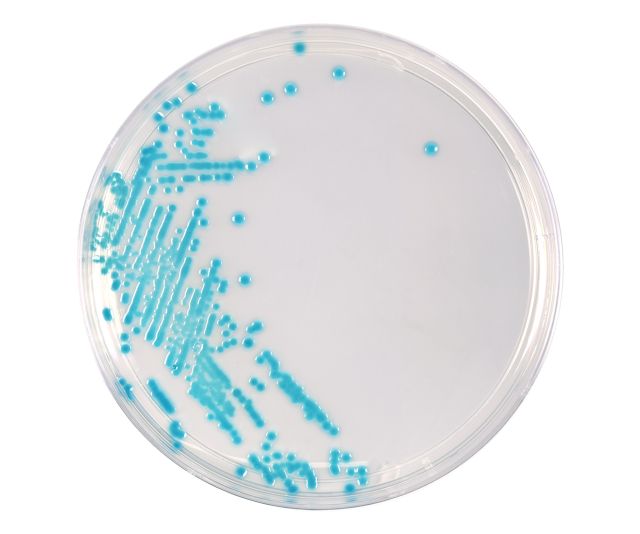

Hardy Diagnostics
HardyCHROM ECC (E. coli and Coliforms), Chromogenic Medium, 15x100mm Plate, 10 per package
HardyCHROM ECC (E. coli and Coliforms), Chromogenic Medium, 15x100mm Plate, 10 per package
Couldn't load pickup availability
HardyCHROM ECC (E. coli and Coliforms), Chromogenic Medium, 15x100mm Plate
HardyCHROM™ ECC is a chromogenic media recommended for the detection, differentiation, and enumeration of Escherichia coli and other coliforms in food, water, or environmental samples based on colony color.
Routine testing to assess the sanitary quality of food and water is directed at the detection and enumeration of indicator organisms rather than pathogens. The coliform group of organisms is recognized as the principal indicator of unsanitary conditions. Coliform organisms are characterized as Gram-negative, lactose-fermenting rods. They are present in the intestinal tract of man and other animals, and non-fecal coliforms are found in many areas of the environment, including in soil and on plants.
Features and Benefits:
- E. coli can be identified as pink to violet colored colonies on the plate.
- Other coliform bacteria will appear as turquoise colonies.
- Organisms other than coliforms or E. coli (including approximately 4% of E. coli strains and most O157 strains) will appear as white or colorless colonies.
- Selective agents have been added to inhibit the growth of Gram-positive and other non-coliform bacteria.
This media is to be stored and incubated in the dark. If you have a light in your refrigerator, incubator, or you leave the media exposed to light on the bench top, Hardy Diagnostics offers free Blok-Boxes. Blok-Box is a reusable cardboard box that holds one sleeve of ten petri plates.
Share